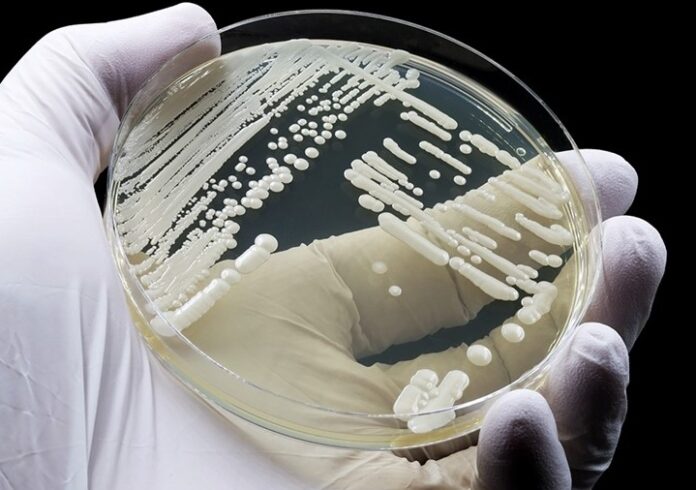
Candidozyma auris

Un hongo resistente a los medicamentos se está extendiendo «rápidamente» en los hospitales de toda Europa, y las autoridades sanitarias piden más esfuerzos para mantenerlo bajo control.
- Este hongo, Candidozyma auris o C. auris, se propaga con facilidad en los centros sanitarios y a menudo elude los fármacos destinados a eliminarlo.
- Las infecciones pueden ser graves, sobre todo para los pacientes ya enfermos, según el nuevo informe del Centro Europeo para la Prevención y el Control de las Enfermedades (ECDC).
- Se notificaron más de 4.000 casos en la Unión Europea y los países cercanos entre 2013 y 2023, con un aumento significativo de los casos a lo largo del tiempo, dijo el ECDC.
España, Grecia, Italia, Rumanía y Alemania han registrado el mayor número de casos en general, y Chipre, Francia y Alemania han notificado brotes recientes. En 2023, el hongo, antes conocido como Candida auris, se detectó en 18 países.
- En algunas partes de Europa, el C. auris está ahora «tan extendido que ya no es posible distinguir entre brotes, es casi endémico en los entornos hospitalarios», declaró Diamantis Plachouras, jefe del equipo de resistencia a los antimicrobianos e infecciones relacionadas con la asistencia sanitaria del ECDC, durante una rueda de prensa.
- Sin embargo, es probable que la cifra real sea inferior a la real. De los 36 países europeos incluidos en el nuevo informe, sólo 17 tienen programas nacionales de vigilancia de C. auris, y sólo 15 cuentan con directrices específicas para prevenir o controlar las infecciones.
- Según el ECDC, la capacidad de este hongo para sobrevivir en superficies y equipos médicos, y para propagarse rápidamente entre pacientes, dificulta su control. No todos los desinfectantes hospitalarios comunes actúan contra él, lo que significa que la limpieza regular no basta para evitar su propagación, añadió Plachouras.
Aunque las personas infectadas pueden tener fiebre y escalofríos, C. auris no presenta un conjunto común de síntomas. Pueden variar en función de si la infección se produce en el torrente sanguíneo, en una herida o en los oídos. Según Plachouras, para detectar brotes es necesario realizar pruebas de laboratorio.
- C. auris se detectó por primera vez en Japón en 2009. Una vez que se detecta por primera vez en un país, tarda sólo unos pocos años en generalizarse, dijo Plachouras. Plachouras explicó que el hongo suele aparecer cuando un paciente ha estado hospitalizado en otro país donde hay C. auris, y luego lo importa al nuevo país.
- El ECDC hizo un llamamiento a los países y sistemas sanitarios para que intensifiquen sus esfuerzos de detección precoz y control a fin de detener la propagación del hongo. «Es algo muy preocupante y sin duda una amenaza para la seguridad de los pacientes en los hospitales de toda Europa», afirmó Plachouras.
El peligroso patógeno surgió por el cambio climático
Hace relativamente poco que sabemos de su existencia: Candidozyma auris –sinónimo de Candida auris– fue descrito por primera vez en 2009 en Japón, en una paciente que padecía una otitis externa (su apellido “auris” significa “del oído”). Pero rápidamente se ha convertido en una amenaza global para la salud pública
- El principal motivo de preocupación es que este hongo microscópico resiste a los antifúngicos empleados habitualmente en el tratamiento de las candidiasis: fluconazol , anfotericina B y, en menor medida, las equinocandinas.
- A esto debemos añadir que es un hongo termotolerante, resistente a la desecación y persistente en la piel humana y en los ambientes hospitalarios, lo que permite su contagio por contacto entre personas
- Cabe recordar aquí también que las micosis, infecciones por hongos microscópicos , causan cada año la muerte de más de 1,5 millones de personas, una mortalidad superior a la causada por la tuberculosis o la malaria.
Además, las micosis resistentes a los tratamientos son cada vez más frecuentes. Por este motivo, la Organización Mundial de la Salud (OMS) publicó en 2022 una lista de hongos de interés prioritario que requieren más atención y recursos para su diagnóstico y tratamiento.
Así actúa Candidozyma auris
A diferencia de otras especies de Candida que forman parte de la microbiota intestinal, Candidozyma auris coloniza la piel. Las personas afectadas eliminan grandes cantidades de hongos, contaminando la ropa, el suelo y los instrumentos médicos ( fómites ).
En estos lugares, el hongo resiste al estrés ambiental y puede persistir durante semanas. Para lograr su erradicación se requiere una limpieza intensiva con productos clorados, luz ultravioleta o vapor de peróxido de hidrógeno y una estricta higiene de manos .
- En general, las micosis superficiales (pie de atleta, tiña o candidiasis vaginal) son muy frecuentes, pero no implican riesgos importantes. Y aunque la mayoría de las personas colonizadas por Candidozyma auris tampoco desarrollan una enfermedad, algunas sí pueden sufrir candidiasis grave:
- La mortalidad es superior al 30 % en personas con inmunodeficiencia cuando penetra en heridas quirúrgicas o en la sangre a través de dispositivos intravenosos. Puede afectar a órganos internos, como el corazón (endocarditis y miocarditis), los huesos (osteomielitis) o el cerebro (meningitis).
Los brotes infecciosos resultan más frecuentes en UCI, unidades de reanimación y residencias geriátricas, donde los pacientes son más vulnerables
El diagnóstico es complejo porque las técnicas convencionales no son suficientes y se requieren técnicas moleculares que no están disponibles en todos los laboratorios. Además, el tratamiento es difícil por la resistencia de muchos de los aislamientos clínicos de Candidozyma auris , lo que obliga, en ocasiones, a combinar fármacos durante semanas para lograr la curación.
Una rápida expansión en Europa
En Europa, según el último informe publicado por el Centro Europeo para la Prevención y el Control de Enfermedades (ECDC) (11 de septiembre de 2025), la propagación de Candidozyma auris mantiene un ritmo acelerado y representa una amenaza para las personas ingresadas en hospitales.
- Hasta 2023, se han declarado 4012 candidiasis y colonizaciones de piel y mucosas en la Unión Europea , con una mayor incidencia en España (1807 infecciones), Grecia (852) e Italia (712). Solo en 2023 hubo 1346 casos en 18 países
Han tenido lugares brotes muy recientes en Chipre, Francia y Alemania, y se ha alcanzado el nivel de endemia en regiones de España, Grecia, Italia y Rumanía en menos de siete años.
La punta del iceberg
- El informe detecta lagunas importantes en los sistemas de vigilancia epidemiológica y en las directrices para la prevención y el control de las infecciones. Aunque la mayoría de los países cuentan con laboratorios de referencia en micología, solo 17 tienen un sistema nacional de vigilancia y 15 disponen de esas directrices.
- Cabe suponer, entonces, que las cifras citadas serían solo la punta del iceberg, ya que se desconoce la frecuencia de la enfermedad fuera de los hospitales. Así mismo, con el aumento del número de infecciones y su distribución geográfica, el control de la epidemia se complica y el riesgo de propagación crece.
España fue el primer país de Europa en notificar un brote de infección hospitalaria por Candidozyma auris . Ocurrió en 2016 en el Hospital Universitario y Politécnico La Fe de Valencia y todavía persiste. Según Javier Pemán, microbiólogo médico de este hospital, “las infecciones siguen concentrándose en los mismos servicios y hospitales, pero hay una mayor concienciación de médicos y pacientes, se han establecido protocolos específicos de vigilancia y se aplican de forma más temprana medidas de control”.
Al calor del cambio climático
La aparición simultánea de diferentes linajes de Candidozyma auris ha reforzado la hipótesis de su origen ambiental. El aumento de la temperatura global asociado al cambio climático habría favorecido a este hongo, resistente a los ciclos de humedad y desecación, y le habría permitido su posterior adaptación al entorno humano.
- En cuanto a su origen, es probable que Candidozyma auris haya saltado desde los marismas al ambiente rural y de aquí al entorno urbano, gracias a la participación de hospedadores-transmisores como aves migratorias, pequeños mamíferos y personas. El aislamiento del hongo en muestras de marismas, playas, piscinas, polvo atmosférico, perros y anfibios refuerza esta hipótesis
- Es su adaptación al aumento de temperatura lo que le habría permitido superar nuestra barrera de endotermia (zona de exclusión térmica): muchos hongos no sobreviven en los mamíferos por su elevada temperatura corporal. La alteración de los nichos ecológicos por la agricultura, el uso de pesticidas o la urbanización habría facilitado este paso.
- Por lo demás, los estudios de secuenciación genómica completa (WGS) han identificado seis linajes o clados de Candidozyma auris , geográficos y genéticamente distintos, con virulencia y resistencia a los antifúngicos variables . Sin embargo, hay candidiasis causada por cualquiera de los linajes en todo el mundo debido al aumento de los desplazamientos de personas.
Actualmente, el reto más importante al que nos enfrentamos es comprender mejor la biología de Candidozyma auris para poder desarrollar formas más eficaces de prevención de su diseminación, métodos de diagnóstico más rápidos y nuevos fármacos y vacunas más eficaces. /PUNTOporPUNTO